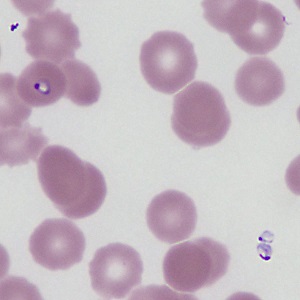
Case469_B Parasitic image

Case #469 – June, 2018
An elderly female sought medical attention for fever, nausea, abdominal pain and generalized weakness. She had no travel outside of the eastern United States. However, she stated a history of tick bites and was presumptively diagnosed with tick-borne relapsing fever based on her clinical presentation. A Giemsa-stained blood smear was ordered and examined. Figures A–D show what was observed on the stained smears. What is your diagnosis? Based on what criteria?
This case and images were kindly provided by the Bureau of Laboratories at the PA Department of Health.

Figure A
Figure B

Figure C

Figure D
Images presented in the dpdx case studies are from specimens submitted for diagnosis or archiving. On rare occasions, clinical histories given may be partly fictitious.
DPDx is an educational resource designed for health professionals and laboratory scientists. For an overview including prevention, control, and treatment visit www.cdc.gov/parasites/.